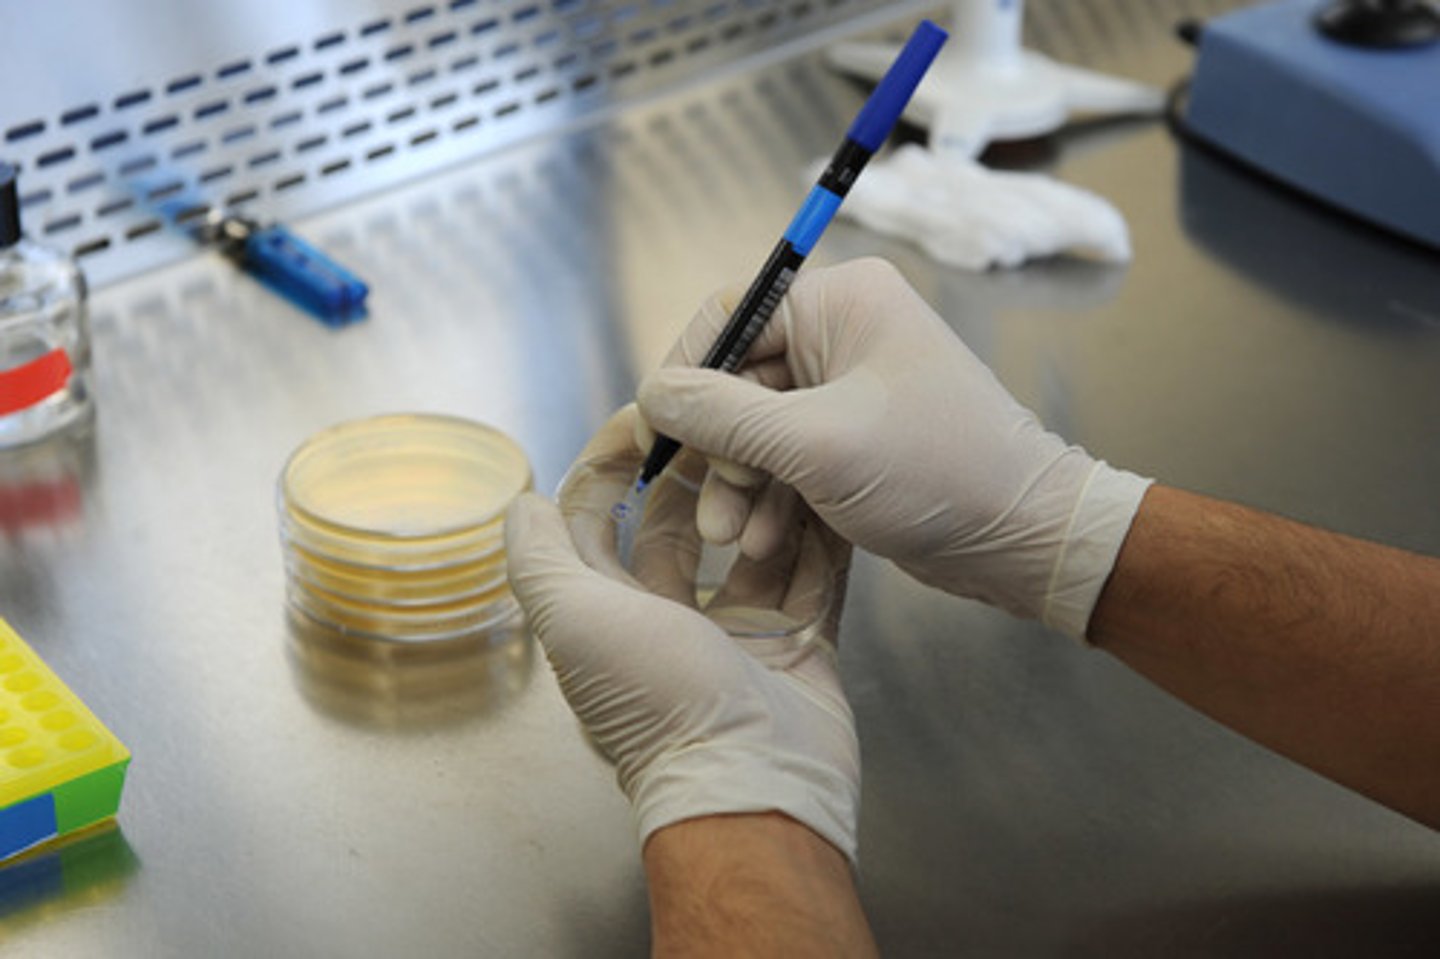
<p>Clinical professionalism in terms of test use/ administration</p>

1/52
Looks like no tags are added yet.
Name | Mastery | Learn | Test | Matching | Spaced |
|---|
No study sessions yet.
The body of knowledge that the test represents
What is a Testing universe

helps focus the test/makes sure all questions relevant/ cover what you want to measure
Why define a testing universe prior to making a test

specifies the characteristics of the test
Test Plan

operational definition of construct
content to be measured ( testing universe)
format for questions
3 things part of test plan

Objective 1 correct answer
Objective vs. Subjective test format

Stimulus to which test takers respond
mechanism for response
2 thing to consider when choosing test format

Sampling ( provide opportunity to sample universe)
Scoring (simple and can be done by computer)
Two things easier for objective testing process
Patterns of responding that result in false/ misleading info
Response style/set

Social Desirability: choose answers that are socially acceptable or present them in favorable light
Acquiescence: select agree for everything
2 different response sets

Administrator (how to set up/run)
Test taker (knowledge needed to complete it)
Scorers (accurately scoring)
3 types of instructions that should be written for new test

helps test developers identify problems/assess how test items perform/ ensure test is valid/reliable before
Why develop a pilot test

item difficulty
Clarity of instructions
Timing
What gained from pilot test

To examine test item performance/ identify what to keep/ modify/ delete
Why conduct test analyses ?

Distractor Analysis
revising item difficulty
2 things that can improve test analysis

Frequency with which an incorrect answer is chosen
if good, incorrect answers will be randomly spread across all alternatives
What info is involved in conducting a distractor analysis

if incorrect answer partially true or obviously incorrect
Writing issue that makes an item poor in distractor analysis

policy/ placement/ counseling/ guidance
3 types of decisions educators make using tests

administrators/ teachers/ testing professionals
Who in educational process makes these decisions

w/o training educators may misinterpret test scores/leads to inaccurate conclusions about student abilities
Why Educators should be trained in psychological testing

improper grade assignment/ placement
2 thing that happen if educators not trained in testing

Unfairly advantage some groups
only measure memorization
2 myths about cognitive ability test

Yes, it suggest that some bias exists but still remains valid predictors of performance as they do measure reasoning, problem solving, and critical thinking
Does data refute the myths?

SES does affect SAT scores but still strong predictor of GPA
SES explain why SAT score predict college GPA?

Norm: score compared with scores of other test takers
Criterion: score compared with an objectively stated standard of achievement
Norm-referenced vs. criterion-referenced tests

Norm identify student standing with others
criterion determines whether student meets learning objectives
Norm-referenced vs. criterion-referenced tests in educational decisions

Assesses student's ability to perform in real-world
Authentic Assessment in educational decision-making

impractical for school systems that need to perform large-scale testing
Why Authentic Assessment rarely used in most educational decision?

Credentials/ training required
Required equipment
audience to which test is administered
requirements of location
What elements should administrator instructions include

simple/ concise/ low reading level
first appear in writing
encouragement/context for answering
What elements should test taker instructions include

written scoring guide
How to interpret score
What elements should test scorer instructions include

The looked at Affirmative Action
What did Fisher v. Texas (for) and SFFA vs Harvard (against) case examine about the selection system?

Structured/semi- structured interviews Clinical interview
Comprehensive Self- report tests
Performance-based/ projective personality tests
Cognitive/ memory testing
Psychological test used in clinical settings


4 categories of psychological test and their use
Clinical interview; ASD parent interview for autism spectrum disorder
Self-report; MMPI objective evaluation personality traits
Projective; Inkblot test reveals unconscious aspects of person's personality projected onto inkblots
Cognitive; WAIS-5 assessment of adult's cognitive abilities
Projective - stimuli elicits responses that reflect unconscious thoughts/ emotions
Objective - structured/ standardized questions w/ clear scoring systems
Projective vs. Objective techniques in clinical assessments

Objective
Projective vs. Objective test used for other than psychological measurement

Ensures clinical methods/ tools/ interventions evidence-based/ effective
Scientific research and clinical professionalism

Clinical professionalism in terms of test use/ administration
Properly trained in administering/ interpreting test evidence must be up-to-date
Must be ethical in use
Reliability and Validity
what form of evidence is necessary for supporting the usage of a psychological test to diagnose/ screen for clinical diagnosis

To examine the reliability/ dependability of perspective employee
Why use credit scores to hire?

Contains more information then just reliability/ dependability
(i.e not being able to build it due to circumstance)
Is it fair to use credit scores in hiring


2 myths about pre-employment testing that prevent businesses from using test
Too expensive
Too difficult/ time-consuming
Structured/standardized interview
Key to interview being a valid predictor

the interviewers are trained on it which increases reliability and validity
Why it increases validity of interview

increase predictive accuracy by standardizing questions/ evaluation criteria
Describe 1 method for accomplishing validity of interview

High - Realistically replicate job setting
Low- simulate task visually/verbally/ with written description
High fidelity vs. low fidelity

High-work sample (simulate environment have them solve a case to choose which is better)
Low- Situational Judgement Test ( tell me what you would do?)
High fidelity vs. low fidelity examples

knowledge, skills, abilities, and other characteristics
KSAO

Psychotherapist
KSAO required for job you want

O - Ability to listen emphatically and empathetically
How to test for one of the KSAOs

Halo effect
Leniency/ severity errors
Recency error
Central tendency errors
Errors in Performance Appraisal

Halo effect- giving better scores to people who are liked more
Describe 1 rating error

Test internal validity ( testing what its supposed to)
Item discrimination ( can discriminate between high and low performers)
item-test correlation

Fairness (judgment call): ethical side of testing
Bias: statistical feature of test
Fairness vs. Bias
